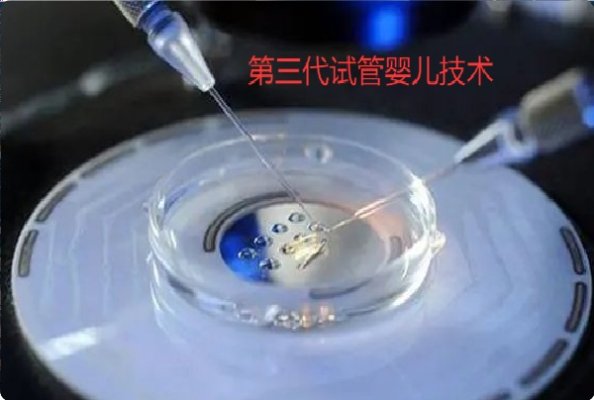
做试管婴儿不能只看运气，做好科学备孕更有利于提高吉尔吉斯斯坦试管婴儿成功率

试管婴儿常见知识大全
试管婴儿技术,也称为体外受精-胚胎移植(IVF-ET),是一种辅助生殖技术,帮助许多不孕不育的夫妇实现了生育的梦想。本文将为您介绍试管婴儿的基本原理、流程以及注意事项,帮助您更好地了解这项技术。
腺肌症对胚胎移植和着床的直接影响
腺肌症,又称子宫腺肌病,是一种常见的妇科疾病,主要表现为子宫内膜异位生长,导致子宫壁增厚、疼痛等症状。对于想要怀孕的女性来说,腺肌症可能会对胚胎移植和着床产生不良影响。本文将从腺肌症的发病机制、
揭秘科学备孕:为何提前三个月至关重要?海外试管顾问的专业解答
在这个快节奏的时代,每一对准父母都渴望以最高效的方式迎接新生命的到来。但你知道吗?科学备孕,其实是一门深奥的学问,其中蕴含着身体的奥秘与自然的智慧。今天,我们将深入探讨,为何科学备孕应提前三个月
试管婴儿早产需要注意哪些事项?
试管婴儿早产虽面临诸多挑战,但只要遵循科学的照护方法,密切配合医疗团队,多数早产儿能逐步追赶正常儿童发育水平。
国庆节和中秋节马上到了,如何提前做好科学备孕
国庆节与中秋节的临近,让空气中弥漫着团圆与欢庆的气息。
卵巢早衰去吉尔吉斯斯坦做试管需要注意哪些事项
在生殖健康领域,卵巢早衰是不少女性面临的困扰,而吉尔吉斯斯坦的试管婴儿技术成为部分卵巢早衰患者的选择。
做试管婴儿不能只看运气,做好科学备孕更有利于提高吉尔吉斯斯坦试管婴儿成功率
在吉尔吉斯斯坦进行试管婴儿治疗,“运气” 并非主导因素。只有做好科学备孕,从优化生殖细胞、改善子宫环境到调整身心状态,全方位为治疗铺路,才能更好地依托当地优质医疗资源,提升试管婴儿成功率,早日实现生
内分泌异常会对促排有哪些影响?爱宝来解答
内分泌异常对吉尔吉斯斯坦促排治疗的影响贯穿卵泡发育、激素调节、卵子质量等多个关键环节。
科学备孕可以提高吉尔吉斯斯坦试管婴儿成功率
在吉尔吉斯斯坦试管婴儿技术不断发展的背景下,科学备孕已成为提高治疗成功率的重要辅助手段。
合理运动更有助孕提高试管婴儿成功率
运动与助孕、试管婴儿成功率的关系并非简单的 “线性关系”,不运动易导致身体代谢失衡,过于运动则可能引发内分泌紊乱,只有合理运动才能为身体创造最佳的受孕环境,帮助提高试管婴儿的成功率。
卵巢早衰去吉尔吉斯斯坦做试管需要注意哪些事项?
卵巢早衰患者前往吉尔吉斯斯坦做试管婴儿,需做好多方面准备,积极配合治疗,保持良好心态,才能更大概率实现生育愿望。
去吉尔吉斯斯坦做试管婴儿为什么要提前做好科学备孕呢?
去吉尔吉斯斯坦做试管婴儿前的科学备孕,并非 “额外准备”,而是治疗成功的 “前置保障”。
-
 腺肌症对胚胎移植和着床的直接影响
腺肌症对胚胎移植和着床的直接影响
腺肌症,又称子宫腺肌病,是一种常见的妇科疾病,主要表现为
2025-04-16 -
 揭秘科学备孕:为何提前三个月至关重要?海
揭秘科学备孕:为何提前三个月至关重要?海
在这个快节奏的时代,每一对准父母都渴望以最高效的方式迎接
2025-04-16 -
 试管婴儿常见知识大全
试管婴儿常见知识大全
试管婴儿技术,也称为体外受精-胚胎移植(IVF-ET),
2018-04-16 -
 科学备孕可以提高吉尔吉斯斯坦试管婴儿成功
科学备孕可以提高吉尔吉斯斯坦试管婴儿成功
在吉尔吉斯斯坦试管婴儿技术不断发展的背景下,科学备孕已成为提
2025-09-13 -
 合理运动更有助孕提高试管婴儿成功率
合理运动更有助孕提高试管婴儿成功率
运动与助孕、试管婴儿成功率的关系并非简单的 “线性关系”,不
2025-09-12